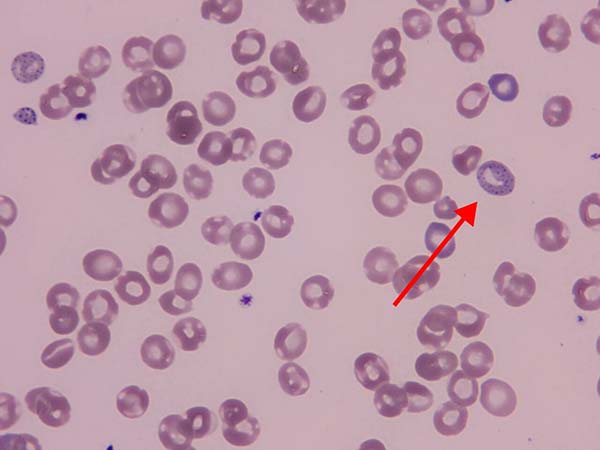
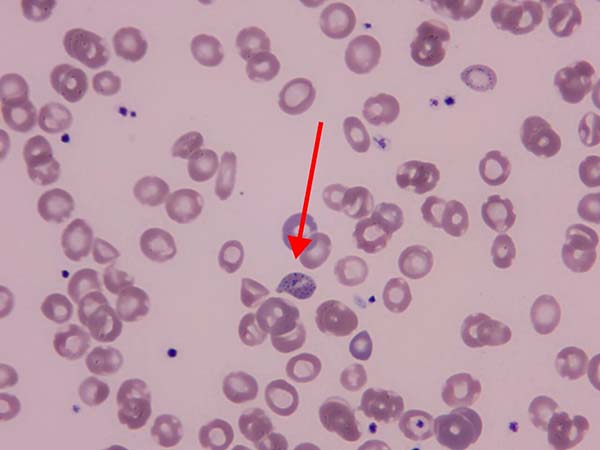

医院新闻
【杨柳探营】两年贫血病因不明,外周血涂片锁定铅中毒
近日,清华大学附属垂杨柳医院检验科血液组通过外周血形态学检查,成功确诊一例无明确铅暴露史的罕见铅中毒性贫血病例,解开了患者长达两年的贫血谜团。患者目前已接受规范驱铅治疗,病情在日渐好转中。
患者为65岁男性,近两年反复出现全身乏力、头晕,血常规提示小细胞低色素性贫血,血红蛋白最低降至56g/L,达到重度贫血标准。患者无明确铅职业暴露或生活接触史。两年间,患者先后排查了消化道出血、恶性肿瘤、甲状腺疾病、营养缺乏等常见贫血诱因,胃肠镜、肝肾功能、肿瘤标志物等检查均未见异常。即便接受补铁、输血等对症治疗,贫血仍未改善,病因始终不明。
面对这一疑难病例,清华大学附属垂杨柳医院检验科血液组在患者外周血涂片形态学检查中,镜下发现嗜碱性点彩红细胞,这一细胞形态是重金属中毒的重要警示信号。随后加做血铅检测,结果显示患者血铅浓度超过700?/L,达到铅中毒标准。经临床科室骨髓穿刺检查进一步证实,患者骨髓造血功能受到铅毒性明显抑制。最终,在检验科的帮助下,患者被确诊为铅中毒性贫血。患者两年来的病情终于得以明确。
目前患者已转至专科医院接受规范驱铅治疗,症状明显改善。该病例的成功确诊,体现了外周血形态学检查在疑难病因筛查中的关键价值,也反映出清华大学附属垂杨柳医院医院检验科在血液系统疾病辅助诊断方面的技术能力。作为临床诊疗的重要支撑平台,检验科将持续加强学科建设,提升疑难病例检测水平,为临床提供更精准的检验依据,切实服务好每一位患者。
科普小课堂:
一、铅中毒为何会诱发贫血?
铅作为剧毒重金属,主要通过呼吸道、消化道侵入人体,可从多个环节破坏机体造血系统,引发顽固性贫血:
1.直接抑制血红蛋白合成关键环节,干扰机体对铁的吸收与利用,诱发难治性小细胞低色素性贫血;
2.损伤红细胞细胞膜结构,引发红细胞溶血,加速红细胞破坏、缩短其寿命;
3.损害肾脏功能,影响促红细胞生成素分泌,进一步加重贫血;
4.干扰红细胞正常代谢,导致细胞内核糖体凝集,形成特征性嗜碱性点彩红细胞。

二、出现这些症状,及时排查铅中毒:
在临床诊疗及家庭健康监测中,即便无明确铅暴露史,出现以下情况,也需及时将铅中毒纳入鉴别诊断,尽早完善外周血形态学、血铅检测:
1.不明原因、持续加重的小细胞低色素性贫血;
2.常规补铁、对症治疗后,贫血症状无任何改善;
3.伴随腹痛、肢体麻木、记忆力减退等疑似重金属中毒伴随症状。
三、铅中毒的治疗与预后:
铅中毒性贫血的治疗核心,在于尽早脱离铅暴露环境加上规范驱铅治疗,同时配合脏器保护、纠正贫血等支持对症处理。若能早期识别、及时干预,患者造血功能可逐步恢复,贫血症状会明显改善,整体预后良好。
四、结语:
不明原因顽固性贫血,切勿局限于缺铁、消化道出血等常见病因。嗜碱性点彩红细胞是重要警示信号,血铅检测是确诊关键。提高对隐匿性铅中毒的识别能力,可有效避免漏诊误诊,改善患者预后。
参考文献
[1] 尚红,王毓三,申子瑜. 全国临床检验操作规程[M]. 第4版. 北京:人民卫生出版社,2015.
[2] 中华人民共和国国家卫生健康委员会. GBZ 37—2024 职业性铅及其无机化合物中毒诊断标准[S]. 北京: 中华人民共和国国家卫生健康委员会, 2024.
[3] 管雪萍,何兰荣,李亚杰,刘盛.1例表现为溶血性贫血的铅中毒病案报道及文献复习[J].微量元素与健康研究,2025,42(5):10-12.DOI:10.3969/j.issn.1005-5320.2025.05.003.
【本文仅限于公益科普及学术交流,如有不适请及时就医。文中检验结果只针对本病例。文中部分资料来源网络及文献,侵删。】
- 标签:
- 检验科









 京公网安备11010502033717号
京公网安备11010502033717号